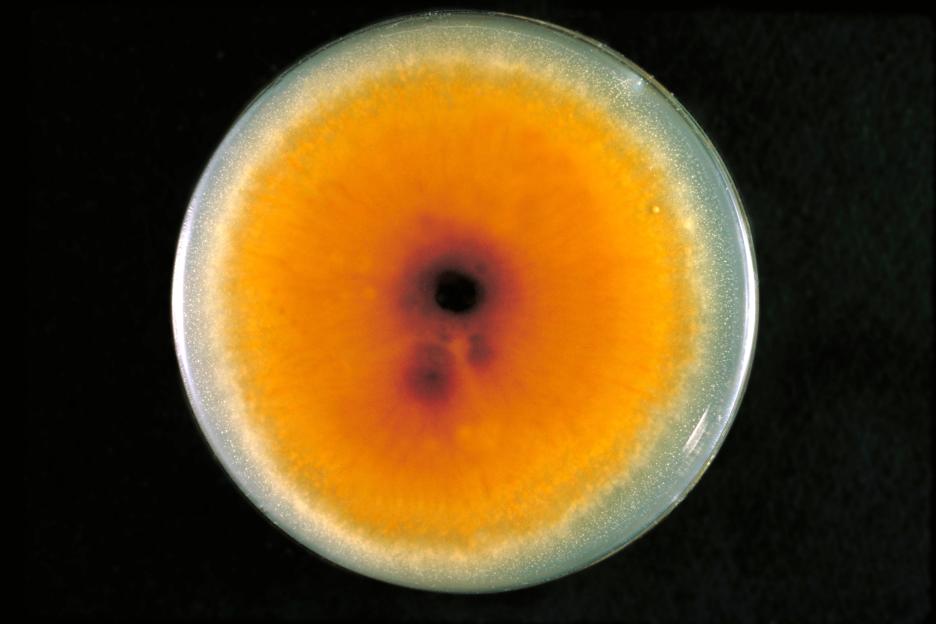
a close up of a yellow circle with a hole in the middle

A HIGHLY contagious strain of fungal ringworm that spreads through sex could already be silently circulating in the UK, experts have warned.
The newly emerged “” – Trichophyton mentagrophytes type VII () – has been spreading globally for just five years.
 A Trichophyton mentagrophytes genotype VII rash on a man’s chestCredit: CDC: Centers for Disease Control and Prevention
A Trichophyton mentagrophytes genotype VII rash on a man’s chestCredit: CDC: Centers for Disease Control and Prevention
Cases have emerged in the US, Canada, Europe and parts of the Middle East, prompting officials to describe it as a “potential public health threat”.
, sometimes referred to as jock itch when it affects the groin, is a fungal infection that spreads through direct contact with an infected person.
Despite its name, it has nothing to do with worms.
It is instead a skin infection caused by a microscopic fungus, known as a dermatophyte, that feeds on dead skin, hair and nail tissue.
And while not fatal, this newly emerging strain has only been recognised in recent years, can be difficult to spot and treat meaning it leaves scarring or lasting skin changes.
The latest alarm comes after a cluster of cases was detected in Minnesota in July 2025, with infections since rising to 13.
But the fungus, which can cause painful rashes across the genitals, thighs and buttocks, did not originate there.
Early clusters were identified in France in 2021 among men who have sex with men, and cases have since been reported in several European countries, including Germany and Spain.
TMVII infections had previously been linked to travel to Southeast Asia.
The , recorded in New York in 2024, involved a patient who developed symptoms after sexual contact during travel to Europe.
Dr Neil Stone, a consultant in infectious diseases and microbiology at University College London Hospitals said: “It is inevitably going to spread worldwide including in the UK and it’s up to doctors to recognise them and do the appropriate testing and seek treatment advice from specialists.”
The fungus spreads via sexCredit: Getty Images – Getty
The fungus spreads via sexCredit: Getty Images – Getty
TMVII is primarily spread through close skin-to-skin contact – including during – but can also pass via shared towels, bedding and clothing.
It causes skin rashes that can appear on the face, limbs, groin and feet, which can take up to three weeks to emerge. It often begins as a small, itchy red patch on the skin, before expanding across the body.
Dr David Denning, an infectious diseases expert at the University of Manchester, said this means there are “very likely that there are undetected cases” in the UK,
“Particularly those in the early stages,” the expert told MailOnline .
And once it does emerge, unlike the neat circular patches typical of other forms of ringworm, this strain can resemble , which may lead to delayed diagnosis and treatment.
And in some regions, NHS dermatology waiting times exceed 18 weeks, meaning patients could remain in agony, and infectious, for prolonged periods.
The warning comes amid growing concern about antifungal resistance.
Experts say many fungal pathogens, including — which causes common infections such as but can be deadly in the bloodstream — are becoming harder to treat.
In 2022, the World Health Organization () listed 19 fungal priority pathogens, warning that rising antifungal resistance has “major implications” for global health.

Ringworm: Everything you need to know
Ringworm is a common fungal infection that can cause a red or silvery ring-like rash on the skin.
It commonly affects arms and legs, but it can appear almost anywhere on the body.
Despite its name, ringworm doesn’t have anything to do with worms.
What does ringworm look like?
Signs typically appear between four and 14 days after your skin comes in contact with the fungi that cause ringworm, including:
- Circular, ring-shaped scales or plaques
- Flat patches with a raised, round border
- Itchy skin
- Hair loss or bald spots in the affected area
What causes ringworm?
Despite its name, a fungus causes ringworm.
This type of fungus naturally lives on your skin, hair and nails. However, when their environment gets hot and damp, the fungi start growing uncontrollably.
You can get this infection anytime your skin comes into contact with the ringworm fungus on someone else’s skin.
How contagious is ringworm?
Ringworm is contagious. It can live on your skin, on surfaces and in soil. The main ways ringworm spreads are:
- Skin-to-skin contact with a person who has ringworm
- Contact with an infected dog, cat or animal (livestock or pets)
- Contact with a contaminated surface, such as a locker room floor or sweaty gym clothes
- Sharing objects with an infected person or animal such as a brush, towel or bedding
- Contaminated soil
How is ringworm treated?
Several nonprescription (over-the-counter) and prescription antifungal medications are available to treat ringworm.
Antifungals come in various forms like creams, gels or powders.
Your healthcare provider can treat more widespread ringworm with oral antifungal medication.
However, trichophyton indotineae is a type of ringworm that is resistent to standard treatments.
Instead, patients end up needing months of hospital-based treatment with itraconazole, a drug that carries a risk of serious toxic side effects, particularly to the liver and heart.







